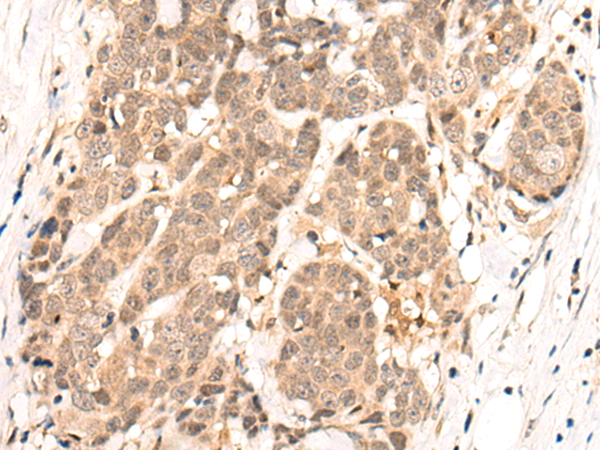

中文名稱 : 兔抗NEK7多克隆抗體
英文名稱 : Anti-NEK7 rabbit polyclonal antibody
抗 原 : NEK7
儲(chǔ) 存 : 冷凍(-20℃)
宿 主 : Rabbit
反應(yīng)種屬 : Human, Mouse, Rat
相關(guān)類別 : 一抗
標(biāo) 記 物 : Unconjugate
克隆類型 : rabbit polyclonal
技術(shù)規(guī)格
|
Background: |
NIMA-related kinases share high amino acid sequence identity with the gene product of the Aspergillus nidulans 'never in mitosis A' gene, which controls initiation of mitosis. Protein kinase which plays an important role in mitotic cell cycle progression. Required for microtubule nucleation activity of the centrosome, robust mitotic spindle formation and cytokinesis. Phosphorylates RPS6KB1. |
|
Applications: |
ELISA, IHC |
|
Name of antibody: |
NEK7 |
|
Immunogen: |
Synthetic peptide of human NEK7 |
|
Full name: |
NIMA related kinase 7 |
|
SwissProt: |
Q8TDX7 |
|
ELISA Recommended dilution: |
5000-10000 |
|
IHC positive control: |
Human esophagus cancer and human breast cancer |
|
IHC Recommend dilution: |
50-300 |

購物車
幫助
021-54845833/15800441009
